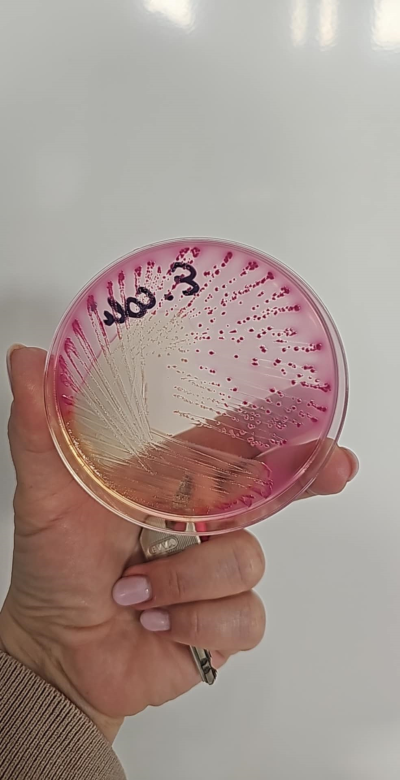

03.11.2025 - spotkanie z okazji uzyskania tytułu profesora przez Panią Prof. Aleksandrę Wesołowską - Kierownika Pracowni Badań nad Mlekiem Kobiecym i Laktacją w Zakładzie Biologii Medycznej




16-17.10.2025 - 8 międzynarodowy kongres EMBA w Wenecji


09.2022 - Warsztaty "Sekrety niewidzialnego świata: techniki mikrobiologiczne" w Zakładzie Biologii Medycznej w ramach 29. Festiwalu Nauki

19-21.05.2025 - Spotkanie w ramach projektu IMAGINE - HMB (EMBA) w Dublinie

04.2025 - Wizyta dydaktyczna w Tibilisi State Medical University w Gruzji w ramach programu "Erasmus+ wyjazdy dla nauczycieli akademickich"





19-21.09.2024 - VI Zjazd Polskiego Towarzystwa Biologii Medycznej




10-11.09.2024 - Spotkanie rozpoczynające projekt IMAGINE - HMB (EMBA) w Mediolanie

25.03.2024 - Spotkanie z delegacją Czeską w Klubie Profesorskim nt. Banków Mleka





12.2023 - Rozdanie Kryształowych Lancetów WUM (nominowana z Zakładu Biologii Medycznej dr Anna Koryszewska-Bagińska)


09.2023 - 27. Festiwal Nauki w Warszawie








06.2023 - Rozdanie Kryształowych Lancetów WUM (nominowana z Zakładu Biologii Medycznej dr Anna Minkiewicz-Zochniak)


11.2022 - Wizyta dydaktyczna w Instituto Politécnico de Bragança w ramach programu "Erasmus+ wyjazdy dla nauczycieli akademickich"
09.2022 - Zajęcia z licealistami w Zakładzie Biologii Medycznej w ramach 26. Festiwalu Nauki
09.2022 Zjazd Polskiego Towarzystwa Mikrobiologicznego w Warszawie
09.2022 XXVI Zjazd Polskiego Towarzystwa Parazytologicznego w Olsztynie




08.2022 Konferencja Parazytologiczna ICOPA w Kopenhadze




14.10.2021 Spotkanie satelitarne VI Zjazdu Europejskich Banków Mleka










